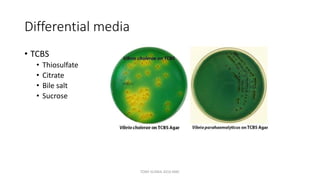
Differential media
• TCBS
• Thiosulfate
• Citrate
• Bile salt
• Sucrose
TONY SCARIA 2010 KMC
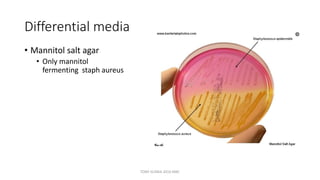
Differential media
• Mannitol salt agar
• Only mannitol
fermenting staph aureus
TONY SCARIA 2010 KMC
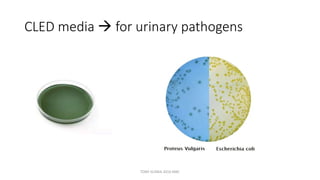
CLED media  for urinary pathogens
TONY SCARIA 2010 KMC
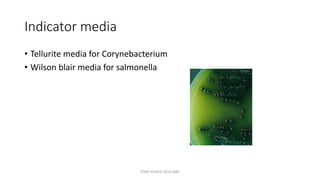
Indicator media
• Tellurite media for Corynebacterium
• Wilson blair media for salmonella
TONY SCARIA 2010 KMC
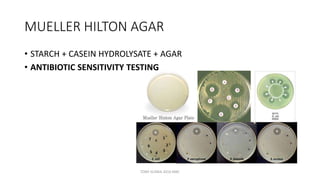
MUELLER HILTON AGAR
• STARCH + CASEIN HYDROLYSATE + AGAR
• ANTIBIOTIC SENSITIVITY TESTING
TONY SCARIA 2010 KMC

This document discusses foundational concepts in microbiology including key figures in the field. Louis Pasteur is identified as the father of microbiology for growing bacteria in liquid media, while Robert Koch is recognized for introducing solid media and discovering the tuberculosis and cholera bacteria. Koch's postulates are also summarized, which are the criteria used to establish a causative relationship between a microbe and a disease. The document also covers topics such as acid-fast staining, culture media, and the effect of temperature and oxygen levels on bacterial growth.